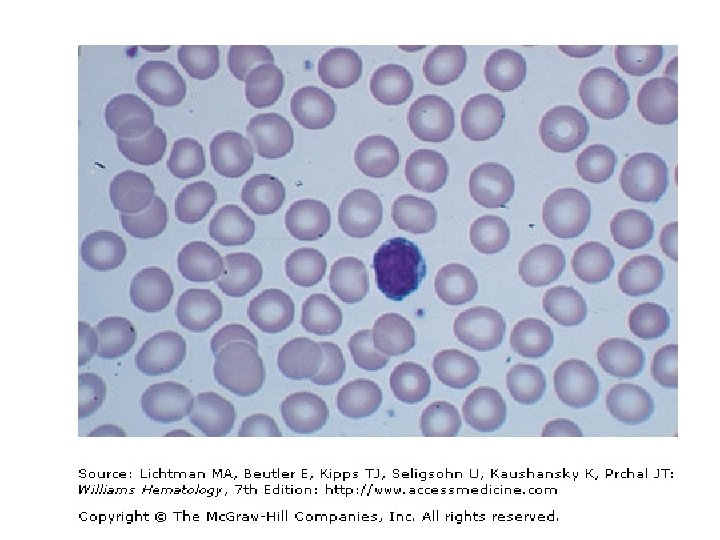
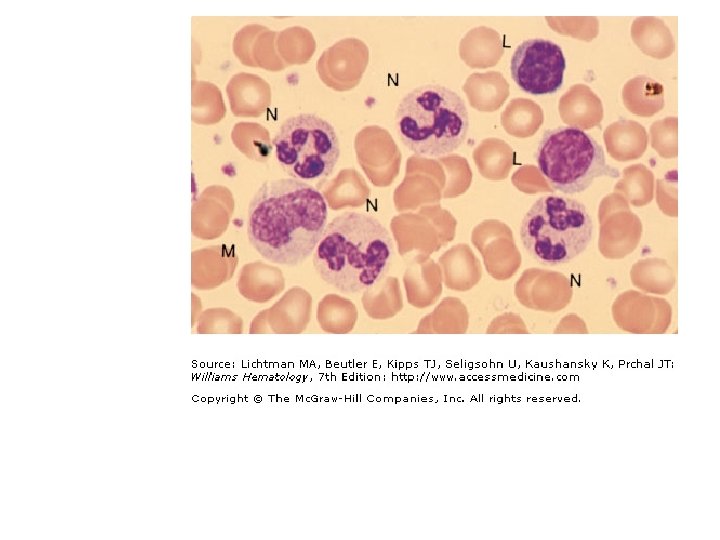
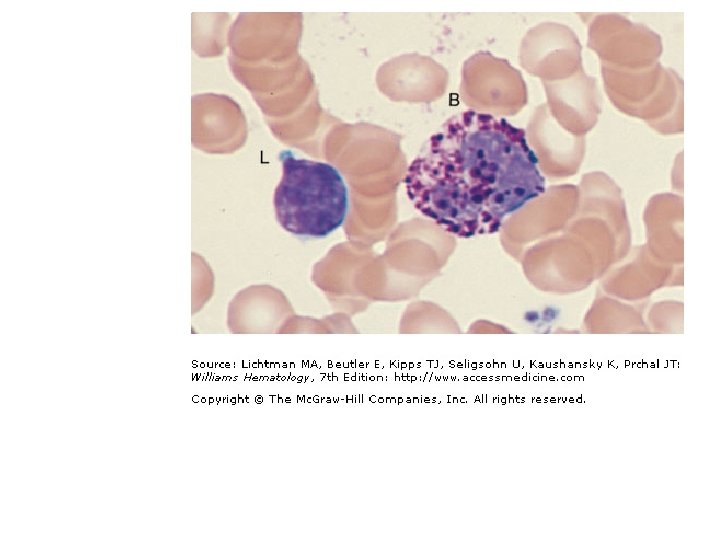
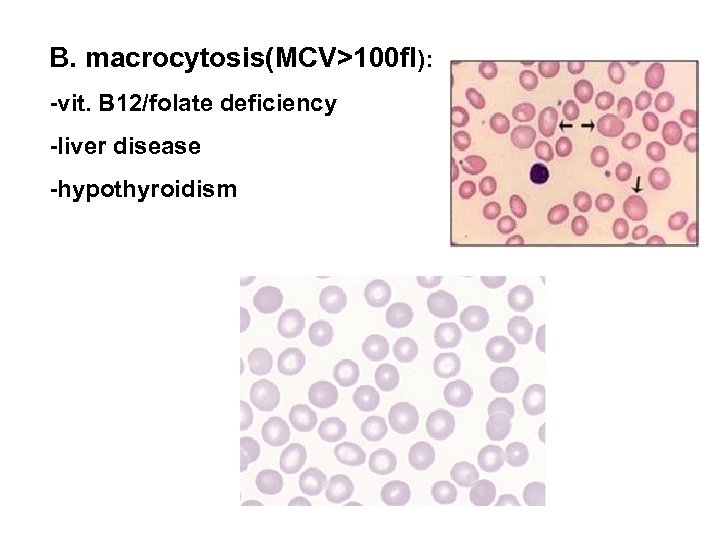
B. macrocytosis(MCV>100 fl): -vit. B 12/folate deficiency -liver disease -hypothyroidism
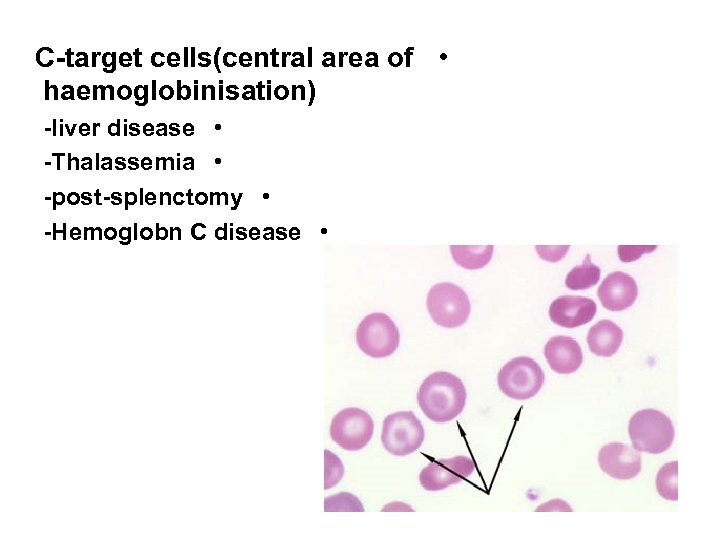
C-target cells(central area of • haemoglobinisation) -liver disease • -Thalassemia • -post-splenctomy • -Hemoglobn
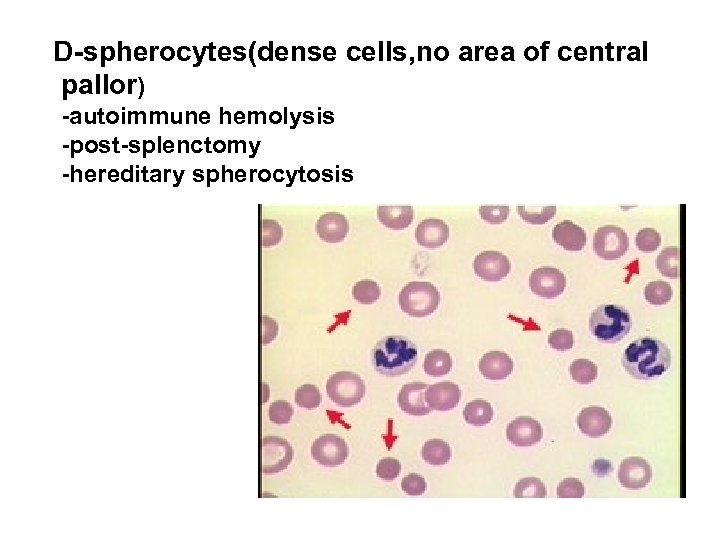
D-spherocytes(dense cells, no area of central pallor) -autoimmune hemolysis -post-splenctomy -hereditary spherocytosis
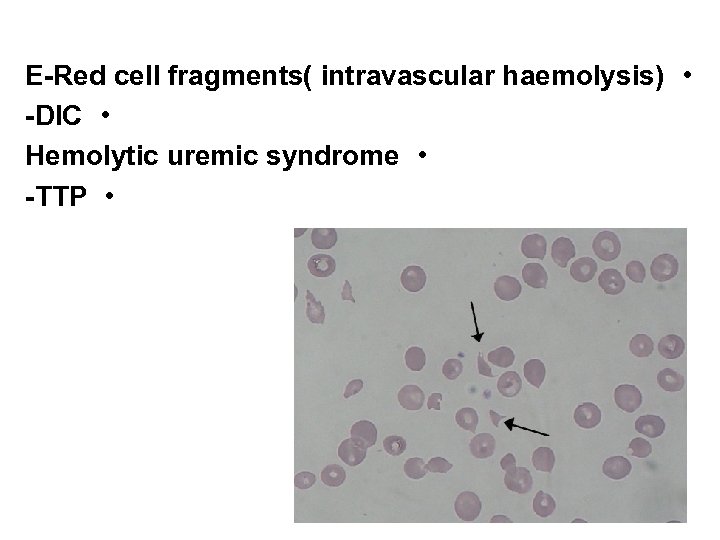
E-Red cell fragments( intravascular haemolysis) • -DIC • Hemolytic uremic syndrome • -TTP •
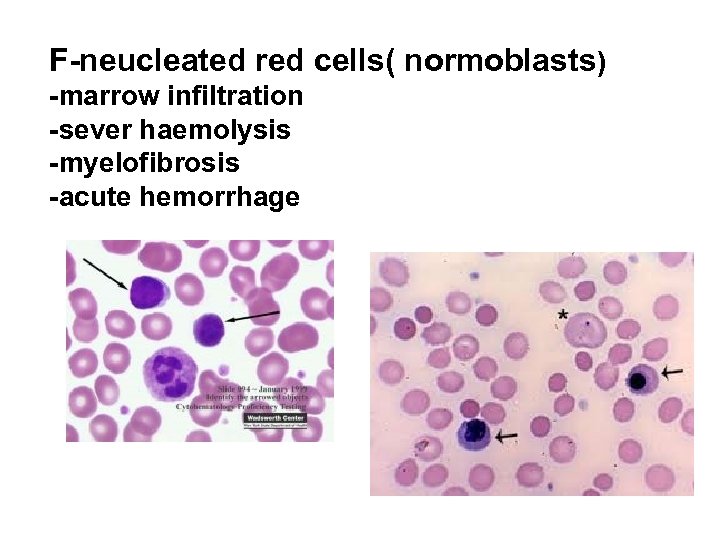
F-neucleated red cells( normoblasts) -marrow infiltration -sever haemolysis -myelofibrosis -acute hemorrhage
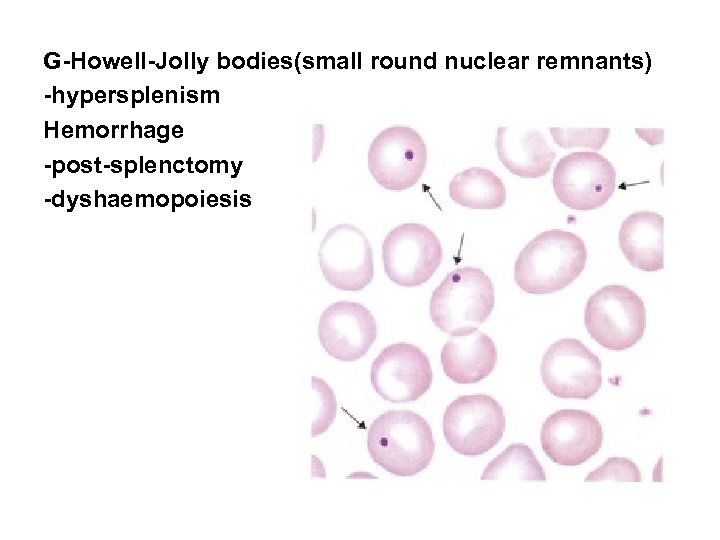
G-Howell-Jolly bodies(small round nuclear remnants) -hypersplenism Hemorrhage -post-splenctomy -dyshaemopoiesis

d2b44d33ca66271a3275fb52458df649.ppt
- Количество слайдов: 47
 HEAMATOLOGY Dr. musa k. hussien Assistant Professor , dep. of internal medicine Al-kindy collage for medicine 5 -10 -2015
HEAMATOLOGY Dr. musa k. hussien Assistant Professor , dep. of internal medicine Al-kindy collage for medicine 5 -10 -2015
 Blood diseases cover a wide spectrum of illnesses, ranging from the anaemias, leukaemias and congenital coagulation disorders. Haematological change may occur as a consequence of disease affecting any system and measurement of haematological parameters is an important part of routine clinical. assessment.
Blood diseases cover a wide spectrum of illnesses, ranging from the anaemias, leukaemias and congenital coagulation disorders. Haematological change may occur as a consequence of disease affecting any system and measurement of haematological parameters is an important part of routine clinical. assessment.
 FUNCTIONAL ANATOMY AND HAEMATOPOIESIS Blood flows throughout the body in the vascular system, and consists of plasma and three cellular components: - red cells, which transport oxygen from the lungs to the tissues - white cells, which protect against infection - platelets, which interact with blood vessels and clotting factors to maintain vascular integrity
FUNCTIONAL ANATOMY AND HAEMATOPOIESIS Blood flows throughout the body in the vascular system, and consists of plasma and three cellular components: - red cells, which transport oxygen from the lungs to the tissues - white cells, which protect against infection - platelets, which interact with blood vessels and clotting factors to maintain vascular integrity
 SITES OF HAEMATOPOIESIS Haematopoiesis: is the process of formation of blood cells In the embryo this occurs initially in the yolk sac, followed by the liver and spleen; by 5 months in utero, haematopoiesis is established in the bone marrow
SITES OF HAEMATOPOIESIS Haematopoiesis: is the process of formation of blood cells In the embryo this occurs initially in the yolk sac, followed by the liver and spleen; by 5 months in utero, haematopoiesis is established in the bone marrow
 At birth, haematopoietic (red) marrow is found in the medullary cavity of all bones, but with age this is progressively replaced by fat (yellow marrow) so that by adulthood, haematopoiesis is restricted to the vertebrae, pelvis, sternum, ribs, clavicles, skull, upper humeri and proximal femora. red marrow can expand in response to increased demands for blood cells.
At birth, haematopoietic (red) marrow is found in the medullary cavity of all bones, but with age this is progressively replaced by fat (yellow marrow) so that by adulthood, haematopoiesis is restricted to the vertebrae, pelvis, sternum, ribs, clavicles, skull, upper humeri and proximal femora. red marrow can expand in response to increased demands for blood cells.
 FORMATION OF BLOOD CELLS Stem cells: All blood cells are derived from a pluripotent stem cell which has the ability to self-renew (make more stem cells) and to differentiate to form any of the blood elements. These comprise only 0. 01% of the total marrow cells As primitive progenitor cells cannot be distinguished morphologically, they are named according to the types of cell (or colony) they form during cell culture experiments -CFU-GM : a stem cell that produces granulocytic and monocytic lines -CFU-E produces erythroid cells -CFU-Meg produces megakaryocytes and ultimately platelets
FORMATION OF BLOOD CELLS Stem cells: All blood cells are derived from a pluripotent stem cell which has the ability to self-renew (make more stem cells) and to differentiate to form any of the blood elements. These comprise only 0. 01% of the total marrow cells As primitive progenitor cells cannot be distinguished morphologically, they are named according to the types of cell (or colony) they form during cell culture experiments -CFU-GM : a stem cell that produces granulocytic and monocytic lines -CFU-E produces erythroid cells -CFU-Meg produces megakaryocytes and ultimately platelets
 The proliferation and differentiation of stem cells and their progeny are under the control of a range of growth factors produced by several cells, including stromal cells and lymphocytes. These growth factors bind to specific receptors on the cell surface and promote not only proliferation and differentiation but also survival and function of mature cells. Some growth factors such as GM-CSF, IL-3, SCF act on a wide number of cell types at both early and late time points. Others, such as erythropoietin (Epo), (G-CSF) and thrombopoietin (Tpo), are lineage-specific Many are synthesized & available for clinical use. .
The proliferation and differentiation of stem cells and their progeny are under the control of a range of growth factors produced by several cells, including stromal cells and lymphocytes. These growth factors bind to specific receptors on the cell surface and promote not only proliferation and differentiation but also survival and function of mature cells. Some growth factors such as GM-CSF, IL-3, SCF act on a wide number of cell types at both early and late time points. Others, such as erythropoietin (Epo), (G-CSF) and thrombopoietin (Tpo), are lineage-specific Many are synthesized & available for clinical use. .
 Red cells: Red cell precursors formed from the erythroid progenitor cells are called erythroblasts or normoblasts. These nucleated cells divide, the nucleus condenses and is extruded from the cell The first non-nucleated red cell is a reticulocyte which still contains ribosomal material in the cytoplasm. then lose their ribosomal material and mature over 3 days, during which time they are released into the circulation. Reticulocytosis: reflect increased erythropoiesis. Red cell production is controlled by erythropoietin, a polypeptide hormone produced by renal tubular cells. Erythropoietin stimulates committed erythroid stem cells to proliferate and decreases maturation time.
Red cells: Red cell precursors formed from the erythroid progenitor cells are called erythroblasts or normoblasts. These nucleated cells divide, the nucleus condenses and is extruded from the cell The first non-nucleated red cell is a reticulocyte which still contains ribosomal material in the cytoplasm. then lose their ribosomal material and mature over 3 days, during which time they are released into the circulation. Reticulocytosis: reflect increased erythropoiesis. Red cell production is controlled by erythropoietin, a polypeptide hormone produced by renal tubular cells. Erythropoietin stimulates committed erythroid stem cells to proliferate and decreases maturation time.
White cells: Granulocytes (neutrophils, eosinophils, basophils) and monocytes are formed from the CFU-GM progenitor cell. The first recognisable granulocyte in the marrow is the myeloblast As the cells divide and mature, the nucleus segments and the cytoplasm acquires specific neutrophilic, eosinophilic or basophilic granules This takes about 14 days. Neutrophill: the most common WBC in the blood of adults, 10 -14 micrometer in diameter multilobulated nucleus containing 2 -5 segments & granules in cytoplasm Function: recognize, ingest, destroy foreign particles & microorganisms
White cells: Granulocytes (neutrophils, eosinophils, basophils) and monocytes are formed from the CFU-GM progenitor cell. The first recognisable granulocyte in the marrow is the myeloblast As the cells divide and mature, the nucleus segments and the cytoplasm acquires specific neutrophilic, eosinophilic or basophilic granules This takes about 14 days. Neutrophill: the most common WBC in the blood of adults, 10 -14 micrometer in diameter multilobulated nucleus containing 2 -5 segments & granules in cytoplasm Function: recognize, ingest, destroy foreign particles & microorganisms
 Every day some 1011 neutrophils enter the circulation, . where cells may be freely circulating or attached to endothelium in the marginating pool. These two pools are equal in size; factors such as exercise or catecholamines increase the number of cells flowing in the blood. Neutrophils spend 6 -10 hours in the circulation before being removed, principally by the spleen. Alternatively, they pass into the tissues and either are consumed in the inflammatory process or undergo apoptotic cell death and phagocytosis by macrophages.
Every day some 1011 neutrophils enter the circulation, . where cells may be freely circulating or attached to endothelium in the marginating pool. These two pools are equal in size; factors such as exercise or catecholamines increase the number of cells flowing in the blood. Neutrophils spend 6 -10 hours in the circulation before being removed, principally by the spleen. Alternatively, they pass into the tissues and either are consumed in the inflammatory process or undergo apoptotic cell death and phagocytosis by macrophages.
Causes of neutrophillia: 1. infection: bacterial, fungal 2. trauma: surgery, burns 3. infarction: Myocardial infarctio, Pulmonary Embolisim, sickle cell crices 4. inflammation: Gout, Ulcerative colitis, crohn’s disease 5. malignancy: solid tumors, Hodgkin's disease 6 - myeloproliferative disease: polycythemia, CML 7. physical: exercise, pregnancy
Causes of neutrophillia: 1. infection: bacterial, fungal 2. trauma: surgery, burns 3. infarction: Myocardial infarctio, Pulmonary Embolisim, sickle cell crices 4. inflammation: Gout, Ulcerative colitis, crohn’s disease 5. malignancy: solid tumors, Hodgkin's disease 6 - myeloproliferative disease: polycythemia, CML 7. physical: exercise, pregnancy
 Causes of nutropenia: 1. infection: viral, bacterial, salmonella, protozoal, malaria 2. drugs: analgesics, anti-inflammatory, anti thyroid, anti arrhythmics, antihypertensive (captopril, nifidipien), anti malarial (chlrolquine, pyrimethamine), anti biotics (cephalosporin, pencillins), anti depressant (psychotic) 3. autoimmune: connective tissue disease 4. alcohol 5. congenital: Kostmann’s syndrome 6. Bone marrow infiltration: leukemia, myleodysplasia
Causes of nutropenia: 1. infection: viral, bacterial, salmonella, protozoal, malaria 2. drugs: analgesics, anti-inflammatory, anti thyroid, anti arrhythmics, antihypertensive (captopril, nifidipien), anti malarial (chlrolquine, pyrimethamine), anti biotics (cephalosporin, pencillins), anti depressant (psychotic) 3. autoimmune: connective tissue disease 4. alcohol 5. congenital: Kostmann’s syndrome 6. Bone marrow infiltration: leukemia, myleodysplasia
 Eosinophils: Represents 1 -6%of the circulating white cells. They are a similar size to neutrophils but have a bi-lobed nucleus and Prominent orange granules on Romanowsky staining. They are Phagocytic, and their granules contain a peroxidase capable of generating oxygen species and proteins involved in the intracellular killing of protozoa and helminthes. they also involved in allergic reactions. .
Eosinophils: Represents 1 -6%of the circulating white cells. They are a similar size to neutrophils but have a bi-lobed nucleus and Prominent orange granules on Romanowsky staining. They are Phagocytic, and their granules contain a peroxidase capable of generating oxygen species and proteins involved in the intracellular killing of protozoa and helminthes. they also involved in allergic reactions. .

 Causes of eosinophillia: 1. allergy: Hay fever, asthma, eczema 2. infection: parasitic 3. Drug hypersensitivity: gold, sulphonamides 4. Skin disease 5. Connective tissue disease: poly arthritis nodosa 6. malegnancy: solid tumors, lymphomas
Causes of eosinophillia: 1. allergy: Hay fever, asthma, eczema 2. infection: parasitic 3. Drug hypersensitivity: gold, sulphonamides 4. Skin disease 5. Connective tissue disease: poly arthritis nodosa 6. malegnancy: solid tumors, lymphomas
 Basophils: 1%of circulating white cells, bind Ig. E antibody on their surface, and exposure to specific antigen results in degranulation with release of histamine, leukotrienes and heparin These cells are involved in hypersensitivity reactions. they contain dense black granules which obscure the nucleus. Causes of basophilia: 1. Myloproliferative disease: polycythemia, CML 2. Inflammation : acute hypersensitivity, ulcerative colitis, crohn’s disease 3. Iron deficiency
Basophils: 1%of circulating white cells, bind Ig. E antibody on their surface, and exposure to specific antigen results in degranulation with release of histamine, leukotrienes and heparin These cells are involved in hypersensitivity reactions. they contain dense black granules which obscure the nucleus. Causes of basophilia: 1. Myloproliferative disease: polycythemia, CML 2. Inflammation : acute hypersensitivity, ulcerative colitis, crohn’s disease 3. Iron deficiency
Monocytes: largest of the white cells, with a diameter of 12 -20 μm migrate into the tissue where they become macrophages which phagocytose debris, apoptotic cells & microorganisms. They produce a variety of cytokines when Activated such as(IL-1), GM-CSF, tumor necrosis factor alpha Causes of monocytosis: 1. infection: bacterial (TB) 2. inflammation: connective tissue disease, ulcerative colitis, crohn’s disease 3. malignancy: solid tumors
Monocytes: largest of the white cells, with a diameter of 12 -20 μm migrate into the tissue where they become macrophages which phagocytose debris, apoptotic cells & microorganisms. They produce a variety of cytokines when Activated such as(IL-1), GM-CSF, tumor necrosis factor alpha Causes of monocytosis: 1. infection: bacterial (TB) 2. inflammation: connective tissue disease, ulcerative colitis, crohn’s disease 3. malignancy: solid tumors

 Lymphocytes In children aged up to 7 years, lymphocytes are the most abundant white cell, two main types T-cells (80%), which can be recognised by their expression of the CD antigens. T cells mediate cellular immunity. B-cell mediate humeral immunity and can be recognised by their expression of immunoglobulin light chain Normal count 1. 5 -4*10^9/L Causes of lymphocytosis: 1. infection: viral, bacterial, bordetella pertussis 2. Lymphoproliferative disease: CLL, lymphoma 3. post-splenectomy
Lymphocytes In children aged up to 7 years, lymphocytes are the most abundant white cell, two main types T-cells (80%), which can be recognised by their expression of the CD antigens. T cells mediate cellular immunity. B-cell mediate humeral immunity and can be recognised by their expression of immunoglobulin light chain Normal count 1. 5 -4*10^9/L Causes of lymphocytosis: 1. infection: viral, bacterial, bordetella pertussis 2. Lymphoproliferative disease: CLL, lymphoma 3. post-splenectomy

 Causes of lymphopenia: 1. inflammation: connective tissue disease 2. Renal faliure 3. Sarcoidosis 4. drugs: steroids, cytotoxics 5. congenital: sever combined immunodeficiency 6. Lymphoma
Causes of lymphopenia: 1. inflammation: connective tissue disease 2. Renal faliure 3. Sarcoidosis 4. drugs: steroids, cytotoxics 5. congenital: sever combined immunodeficiency 6. Lymphoma
 Platelets are derived from megakaryocytes. Megakaryocytic stem cells (CFU-Meg) divide to form a megakaryoblast mature megakaryocytes are large cells with several nuclei and cytoplasm containing platelet granules The formation and maturation of megakaryocytes are under the influence of Tpo Platelets are discoid with a diameter of 2 -4 micrometer.
Platelets are derived from megakaryocytes. Megakaryocytic stem cells (CFU-Meg) divide to form a megakaryoblast mature megakaryocytes are large cells with several nuclei and cytoplasm containing platelet granules The formation and maturation of megakaryocytes are under the influence of Tpo Platelets are discoid with a diameter of 2 -4 micrometer.



 INVESTIGATION OF DISEASES OF THE BLOOD 1. THE FULL BLOOD COUNT: the measurement of the number of circulating (RBC), (WBC) and platelets, the concentration of (Hb) and the characteristics of the red cells blood is processed through blood analysers to measure the different haematological parameters. These include: 1. numbers of circulating cells 2. the proportion of red cells present in blood (the haematocrit, Hct) 3. red cell indices which give information about the size of red cells (mean cell volume, MCV) and the amount of haemoglobin present in the red cells (mean cell haemoglobin, MCH) 4. detect the different types of white blood cell and give automated white cell differential counts
INVESTIGATION OF DISEASES OF THE BLOOD 1. THE FULL BLOOD COUNT: the measurement of the number of circulating (RBC), (WBC) and platelets, the concentration of (Hb) and the characteristics of the red cells blood is processed through blood analysers to measure the different haematological parameters. These include: 1. numbers of circulating cells 2. the proportion of red cells present in blood (the haematocrit, Hct) 3. red cell indices which give information about the size of red cells (mean cell volume, MCV) and the amount of haemoglobin present in the red cells (mean cell haemoglobin, MCH) 4. detect the different types of white blood cell and give automated white cell differential counts
 2. Blood film examination: Mandatory to detect RBC morphology, Hetrogenecity in RBC size (anisocytosis) shape (poikilocytosis) specific RBC morphologic abnormalities, WBC, platelet abnormalities may be seen Common RBC appearances & their causes: A. Microcytosis (reduced average cell size MCV< 76 fl) - Iron deficiency anemia Thalassaemia - Sideroblastic anemia
2. Blood film examination: Mandatory to detect RBC morphology, Hetrogenecity in RBC size (anisocytosis) shape (poikilocytosis) specific RBC morphologic abnormalities, WBC, platelet abnormalities may be seen Common RBC appearances & their causes: A. Microcytosis (reduced average cell size MCV< 76 fl) - Iron deficiency anemia Thalassaemia - Sideroblastic anemia
B. macrocytosis(MCV>100 fl): -vit. B 12/folate deficiency -liver disease -hypothyroidism
B. macrocytosis(MCV>100 fl): -vit. B 12/folate deficiency -liver disease -hypothyroidism
C-target cells(central area of • haemoglobinisation) -liver disease • -Thalassemia • -post-splenctomy • -Hemoglobn C disease •
C-target cells(central area of • haemoglobinisation) -liver disease • -Thalassemia • -post-splenctomy • -Hemoglobn C disease •
D-spherocytes(dense cells, no area of central pallor) -autoimmune hemolysis -post-splenctomy -hereditary spherocytosis
D-spherocytes(dense cells, no area of central pallor) -autoimmune hemolysis -post-splenctomy -hereditary spherocytosis
E-Red cell fragments( intravascular haemolysis) • -DIC • Hemolytic uremic syndrome • -TTP •
E-Red cell fragments( intravascular haemolysis) • -DIC • Hemolytic uremic syndrome • -TTP •
F-neucleated red cells( normoblasts) -marrow infiltration -sever haemolysis -myelofibrosis -acute hemorrhage
F-neucleated red cells( normoblasts) -marrow infiltration -sever haemolysis -myelofibrosis -acute hemorrhage
G-Howell-Jolly bodies(small round nuclear remnants) -hypersplenism Hemorrhage -post-splenctomy -dyshaemopoiesis
G-Howell-Jolly bodies(small round nuclear remnants) -hypersplenism Hemorrhage -post-splenctomy -dyshaemopoiesis
 H-Polychromasia(young red cellsreticulocytes present) -hemolysis, acute haemorrhage -increased red cells turn over
H-Polychromasia(young red cellsreticulocytes present) -hemolysis, acute haemorrhage -increased red cells turn over
 I-Basophilic stippling(abnormal ribosomes appear as. Blue dots). dyshaematopoiesis. lead poisoning
I-Basophilic stippling(abnormal ribosomes appear as. Blue dots). dyshaematopoiesis. lead poisoning
 3. Bone marrow examination: Bone marrow aspirate is used to assess the composition & morphology of heamatopoitic cells or abnormal infiltrates Atrephine biopsy is superior for assessing marrow cellularty, marrow fibrosis & infilteration by abnormal cells
3. Bone marrow examination: Bone marrow aspirate is used to assess the composition & morphology of heamatopoitic cells or abnormal infiltrates Atrephine biopsy is superior for assessing marrow cellularty, marrow fibrosis & infilteration by abnormal cells
 PRESENTING PROBLEMS IN BLOOD DISEASE Anaemia refers to a state in which the level of haemoglobin in the blood is below the normal range appropriate for age and sex. factors, including pregnancy and altitude, also affect haemoglobin levels and must be taken into account when considering whether an individual is anaemic. The clinical assessment and investigation of anaemia must not only assess its severity but also define the underlying cause.
PRESENTING PROBLEMS IN BLOOD DISEASE Anaemia refers to a state in which the level of haemoglobin in the blood is below the normal range appropriate for age and sex. factors, including pregnancy and altitude, also affect haemoglobin levels and must be taken into account when considering whether an individual is anaemic. The clinical assessment and investigation of anaemia must not only assess its severity but also define the underlying cause.
 The clinical features of anaemia reflect diminished oxygen supply to the tissues. A rapid onset of anaemia (e. g. due to blood loss) causes more profound symptoms than a gradually developing anaemia. Individuals with cardiorespiratory disease are more susceptible to symptoms of anaemia.
The clinical features of anaemia reflect diminished oxygen supply to the tissues. A rapid onset of anaemia (e. g. due to blood loss) causes more profound symptoms than a gradually developing anaemia. Individuals with cardiorespiratory disease are more susceptible to symptoms of anaemia.
 Causes: 1. Decrease or ineffective marrow production: Lack of iron, vit B 12, folate - -renal failure -anaemia of chronic disease- Hypoplasia - Invasion by malignant cells 2. Periphral causes: oss -heamolysis -hypersplenism
Causes: 1. Decrease or ineffective marrow production: Lack of iron, vit B 12, folate - -renal failure -anaemia of chronic disease- Hypoplasia - Invasion by malignant cells 2. Periphral causes: oss -heamolysis -hypersplenism
 • Iron deficiency anaemia is the most common type of anaemia world-wide. A thorough gastrointestinal history is important, looking in page particular for symptoms of blood loss. 997 Clinical assessment Menorrhagia is a common cause of page 998 anaemia in pre-menopausal females, so women should always be asked about their periods.
• Iron deficiency anaemia is the most common type of anaemia world-wide. A thorough gastrointestinal history is important, looking in page particular for symptoms of blood loss. 997 Clinical assessment Menorrhagia is a common cause of page 998 anaemia in pre-menopausal females, so women should always be asked about their periods.
 • A dietary history should assess the intake of iron and folate which may become deficient in comparison to needs (e. g. in pregnancy or during periods of rapid growth. • Past medical history may reveal a disease which is known to be associated with anaemia, such as rheumatoid arthritis (the anaemia of chronic disease), or previous surgery (e. g. resection of the stomach or small bowel which may lead to malabsorption of iron and/or vitamin B 12).
• A dietary history should assess the intake of iron and folate which may become deficient in comparison to needs (e. g. in pregnancy or during periods of rapid growth. • Past medical history may reveal a disease which is known to be associated with anaemia, such as rheumatoid arthritis (the anaemia of chronic disease), or previous surgery (e. g. resection of the stomach or small bowel which may lead to malabsorption of iron and/or vitamin B 12).
 Family history and ethnic background may raise suspicion of haemolytic anaemias such as the haemoglobinopathies and hereditary spherocytosis. Pernicious anaemia may also be familial. A drug history may reveal the ingestion of drugs which cause blood loss (e. g. aspirin and anti-inflammatory drugs), haemolysis or aplasia
Family history and ethnic background may raise suspicion of haemolytic anaemias such as the haemoglobinopathies and hereditary spherocytosis. Pernicious anaemia may also be familial. A drug history may reveal the ingestion of drugs which cause blood loss (e. g. aspirin and anti-inflammatory drugs), haemolysis or aplasia
 On examination, , *a patient may be found to have a right iliac fossa mass due to an underlying caecal carcinoma. *Haemolytic anaemias can cause jaundice. *Vitamin B 12 deficiency may be associated with neurological signs including peripheral neuropathy, dementia and signs of subacute combined degeneration of the cord. *Sickle-cell anaemia may result in leg ulcers, stroke or • features of pulmonary hypertension. Anaemia may be multifactorial and the lack of specific symptoms and signs does not rule out silent pathology.
On examination, , *a patient may be found to have a right iliac fossa mass due to an underlying caecal carcinoma. *Haemolytic anaemias can cause jaundice. *Vitamin B 12 deficiency may be associated with neurological signs including peripheral neuropathy, dementia and signs of subacute combined degeneration of the cord. *Sickle-cell anaemia may result in leg ulcers, stroke or • features of pulmonary hypertension. Anaemia may be multifactorial and the lack of specific symptoms and signs does not rule out silent pathology.


